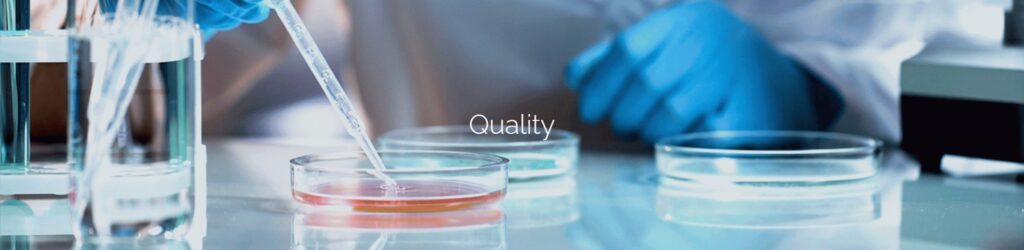

Export companies of sauce products from Europe


OLIVERA D’ATENEA export company of sauce products from Spain
Artisanal Sauces and Dressings
About us

OUR COMMITMENT
At Técnicas de Elaboración de Salsas we have a challenge: With natural, top quality products, to produce the best sauces and dressings, to contribute to the enjoyment of food for the whole family.

Producers
Our commitment to quality is backed by the main food certifications. We subject all the products we make to strict quality controls that guarantee their safety.

Quality
Our commitment to quality is backed by the main food certifications.

Sustainability
Tackling the climate emergency through tasty, healthy and sustainable food is one of our main objectives.
Producers

In addition to marketing our own brands, we manufacture for private labels and distributor brands (MDD). We collaborate with them in the development of new products, meeting the demands and specifications required by our customers.




At Técnicas de Elaboración de Salsas, we specialize in creating all types of sauces and dressings, adapting to the specific needs and formats of each client.

Our products are synonymous with quality and trust.
With over 20 years of experience, we are a team committed to innovation, technology, and efficiency, providing sustainable solutions to our clients.
We offer a comprehensive service that covers everything from product design and development to the final presentation.
The high performance of our production lines—adaptable to different formats and capacities—and our commitment to the highest quality through the use of cutting-edge technology have enabled us to achieve top-level competitiveness, offering our clients the best value for money.
We carefully select the best suppliers for sourcing our raw materials and follow strict production procedures.

Quality
Our commitment to quality is backed by the leading food certifications

Our facilities are equipped with the latest technologies in food production systems, with strict control over raw materials and sanitary conditions, in full compliance with current European legislation.
The traceability of all our products begins with an advanced management system for selecting and sourcing raw materials, carefully overseeing every stage of the production process, as well as the nutritional values and organoleptic properties.



Compliance with this entire quality and food safety system has enabled us to obtain the IFS Food (International Food Standard) certification.
This certification ensures compliance with European food safety standards in manufacturing, packaging, and storage.
We have an R&D&I department and a professional team with many years of experience in sauce production for the food industry.
Day by day, our production processes undergo rigorous controls and continuous analysis of the final product.



SAUCES


Calçots sauce
Traditional sauce essential to dip the Calçots in a calçotada. There is no calçotada without the Olivera d’Atenea Calçots Sauce!

Gran Romesco Sauce GLUTEN FREE
Gran Romesco Sauce is a traditional sauce made with ingredients from the Mediterranean diet.

Romesco Sauce
One of the most traditional sauces in Tarragona coast. Of marine origin, this traditional sauce is made with a rich base of tomato, olive oil, garlic and toasted nuts, that give the Romesco sauce a unique an incomparable flavor.

Brava Sauce Olivera d’Atenea
The Brava Sauce is one of the most popular sauces in the spanish cuisine.
Characteristic for its spiciness, the Brava Sauce is issential to savor the authentic “patatas bravas”, and to give a daring touch to all kind of meat or fish recipes.

Vegan Mayovegana Sauce
Mayovegana sauce is a vegan mayonnaise-type sauce.
Its flavour and texture is reminiscent of mayonnaise sauce but, unlike mayonnaise, Mayovegana is egg and dairy free. It is a 100% vegan sauce.

Black Garlic Allioli
With its fruity notes and a slight of licorice, black garlic provides a unique and special flavor; the fifth flavor, “umami”.

Xató Sauce
The Xató Sauce is the dressing of the Xatonada, a typical Mediterranean salad made with endive, cod, anchovies, tuna and Arbequina olives.

Allioli Sauce
The Allioli or Aioli is a typical sauce of a Mediterranean cuisine that is made with garlic and oil.

Mushroom Sauce
The Mushroom Sauce is the ideal companion ffor stuffed pasta dishes such as raviolis or tortellinis.
it is also delicious with grilled meat, fish and vegetables.

Olivada Sauce
Exquisite Olivada or Sauce of black olives from Bajo Aragón, highly appreciated for their great flavor and intense aroma.

Green Olivada Sauce
Exquisite olive sauce made with 2 varieties of olives: arbequina and green, which stand out for their incredible aroma.

Pesto Sauce
A classic of traditional Italian cuisine, whose base is fresh basil that gives it its characteristic flavor.

Vegan Bolognese Sauce
A 100% vegetable sauce with all the taste of the traditional Bolognese sauce.
Made with the highest quality ingredients, the Vegan Bolognese Sauce is perfect to accompany all kinds of pasta, pizza, lasagna dishes… And to prepare delicious stuffed aubergines.

Quinoa Sauce
Quinoa Sauce is a light and refreshing sauce perfect to accompany meats and pasta dishes.
It is also a fantastic salad dressing for rice, pasta, quinoa…

Salsa Ragú de Verduras
La Salsa de Setas es la compañera ideal de platos de pasta rellena como raviolis o tortellinis. También resulta exquisita con carnes a la brasa y pescados.

Kale Sauce
Kale Sauce can be used as a sauce for noodles. Special to complement all types of grilled meats (chicken, turkey, etc.).
Perfect seasoning for salads: quinoa, rice, pasta… And ideal with grilled potatoes.

Carrot Sauce to Vermouth
This sauce with a slightly sweet flavor is ideal to accompany any dish, whether vegetable or meat, as well as pasta and rice.
Carrot is a rich source of antioxidants.

Truffled Asparagus Sauce
Exquisite sauce with a very delicate texture and light truffle flavour, ideal to accompany baked vegetable and meat dishes.
It is also perfect to accompany pasta and rice dishes.
And surprising with some scrambled eggs.

Argentina Sauce
Argentina sauce is made from tomato and spices.
It is an ideal sauce to accompany meat and vegetables on the barbecue, and to give a different touch to sandwiches and hamburgers.

Barbecue Sauce
Deliciosa salsa para acompañar carnes que, como su nombre indica, se elaboran a la parrilla.
También resulta deliciosa con pescados y verduras.

Chocolate Sauce with Jalapeños
This sauce with a slight touch of spiciness is perfect for roasts and meat stews.
The slightly spicy touch is provided by the jalapeño chili, a variety of hot pepper native to the city of Jalapa.

Pumpkin Sauce with Chilli
This pumpkin sauce is the perfect accompaniment for pasta dishes and also for roasted vegetables.
The mild flavor of the vegetables and pumpkin is complemented by the spiciness provided by the chipotle pepper.
ORGANIC SAUCES


Organic Brava Sauce
The Brava Sauce is one of the most popular sauces in the spanish cuisine.
Characteristic for its spiciness, the Brava Sauce is issential to savor the authentic “patatas bravas”, and to give a daring touch to all kind of meat or fish recipes.

Organic Brava Sauce
Made in a traditional way with tomatoes from organic farming and the right combination of spices, that give it the characteristic flavor of this well-known American sauce.

Organic Allioli Sauce
The Allioli or Aioli is a typical sauce of a Mediterranean cuisine that is made with garlic and oil.

Organic MayoVegana Sauce
It is egg free, dairy free and gluten free.
It’s a sauce with a light texture and smooth flavor, with a slight touch of turmeric, which makes this sauce a product with an exceptional flavor.

Organic Romesco Sauce
One of the most traditional sauces in Tarragona coast. Of marine origin, this traditional sauce is made with a rich base of tomato, olive oil, garlic and toasted nuts, that give the Romesco sauce a unique an incomparable flavor.

Organic Green Olivada Sauce
Exquisite olive sauce made with 2 varieties of olive: arbequina and green, which stand out for their incredible aroma.

Organic Pesto Sauce
Pesto sauce is one of the most famous sauces in the world and stands out for its incredible basil flavor.
This aromatic sauce, of Genovese origin, is perfect to accompany all kinds of recipes, in addition to the typical pasta dishes. Also to flavor meat and fish.

Organic Olivada Sauce
Made with black olives from Bajo Aragón, highly appreciated for their pleasant and intense flavor, from organic farming.
SALAD DRESSINGS


Garlic Vinaigrette
The perfect dressing for all kind of meats, and also for salads and carpaccios.
The Olivera d’Atenea Garlic Vinaigrette is also perfect for adding a touch of flavour to pasta dishes.

Apple Vinaigrette
Apple Vinaigrette is an exquisite dressing for all kinds of dishes, from salads to fruit salads.

Balsamic Vinaigrette
With Balsamic Vinaigrette you can flavor all types of salads.
It is also ideal for flavoring stir-fries, stews, roast meats… And if you want to give an Asian touch to your dishes, mix it with a few drops of soy sauce.

Orange Vinaigrette
Aporta a tus platos un afrutado sabor a naranja y un frescor revitalizante.
Un exquisito y sorprendente aliño para todo tipo de platos, desde ensaladas hasta macedonias de fruta, gracias a su aromático y refrescante sabor.

Mango Vinaigrette
La Vinagreta de mango es un aliño perfecto para ensaladas tropicales gracias a su peculiar sabor un tanto ácido y afrutado.

Raspberry Vinaigrette
An exquisite and surprising dressing for all kinds of dishes, whether sweet or savory: meat carpaccios, tuna, salmon…
It’s ideal for salad lovers who enjoy a light sweet-and-sour flavor and, why not, for preparing fruit salads with a mix of flavors.

Mustard Vinaigrette
Mustard Vinaigrette enhances the flavor of all types of salads and especially pasta ones.
It is also ideal for carpaccio, and especially for duck magret. It is the essential dressing for unconditional mustard lovers.
Contact
📞 Telephone
(+34) 977 338 170
✉️ Email
info[@]oliveradatenea.com
📍 Address
C/ Víctor Català, 19
P.I. Agro-Reus
43206 – Reus (Tarragona)
Spain
Copyright 2025 © exportsfromeurope.com




